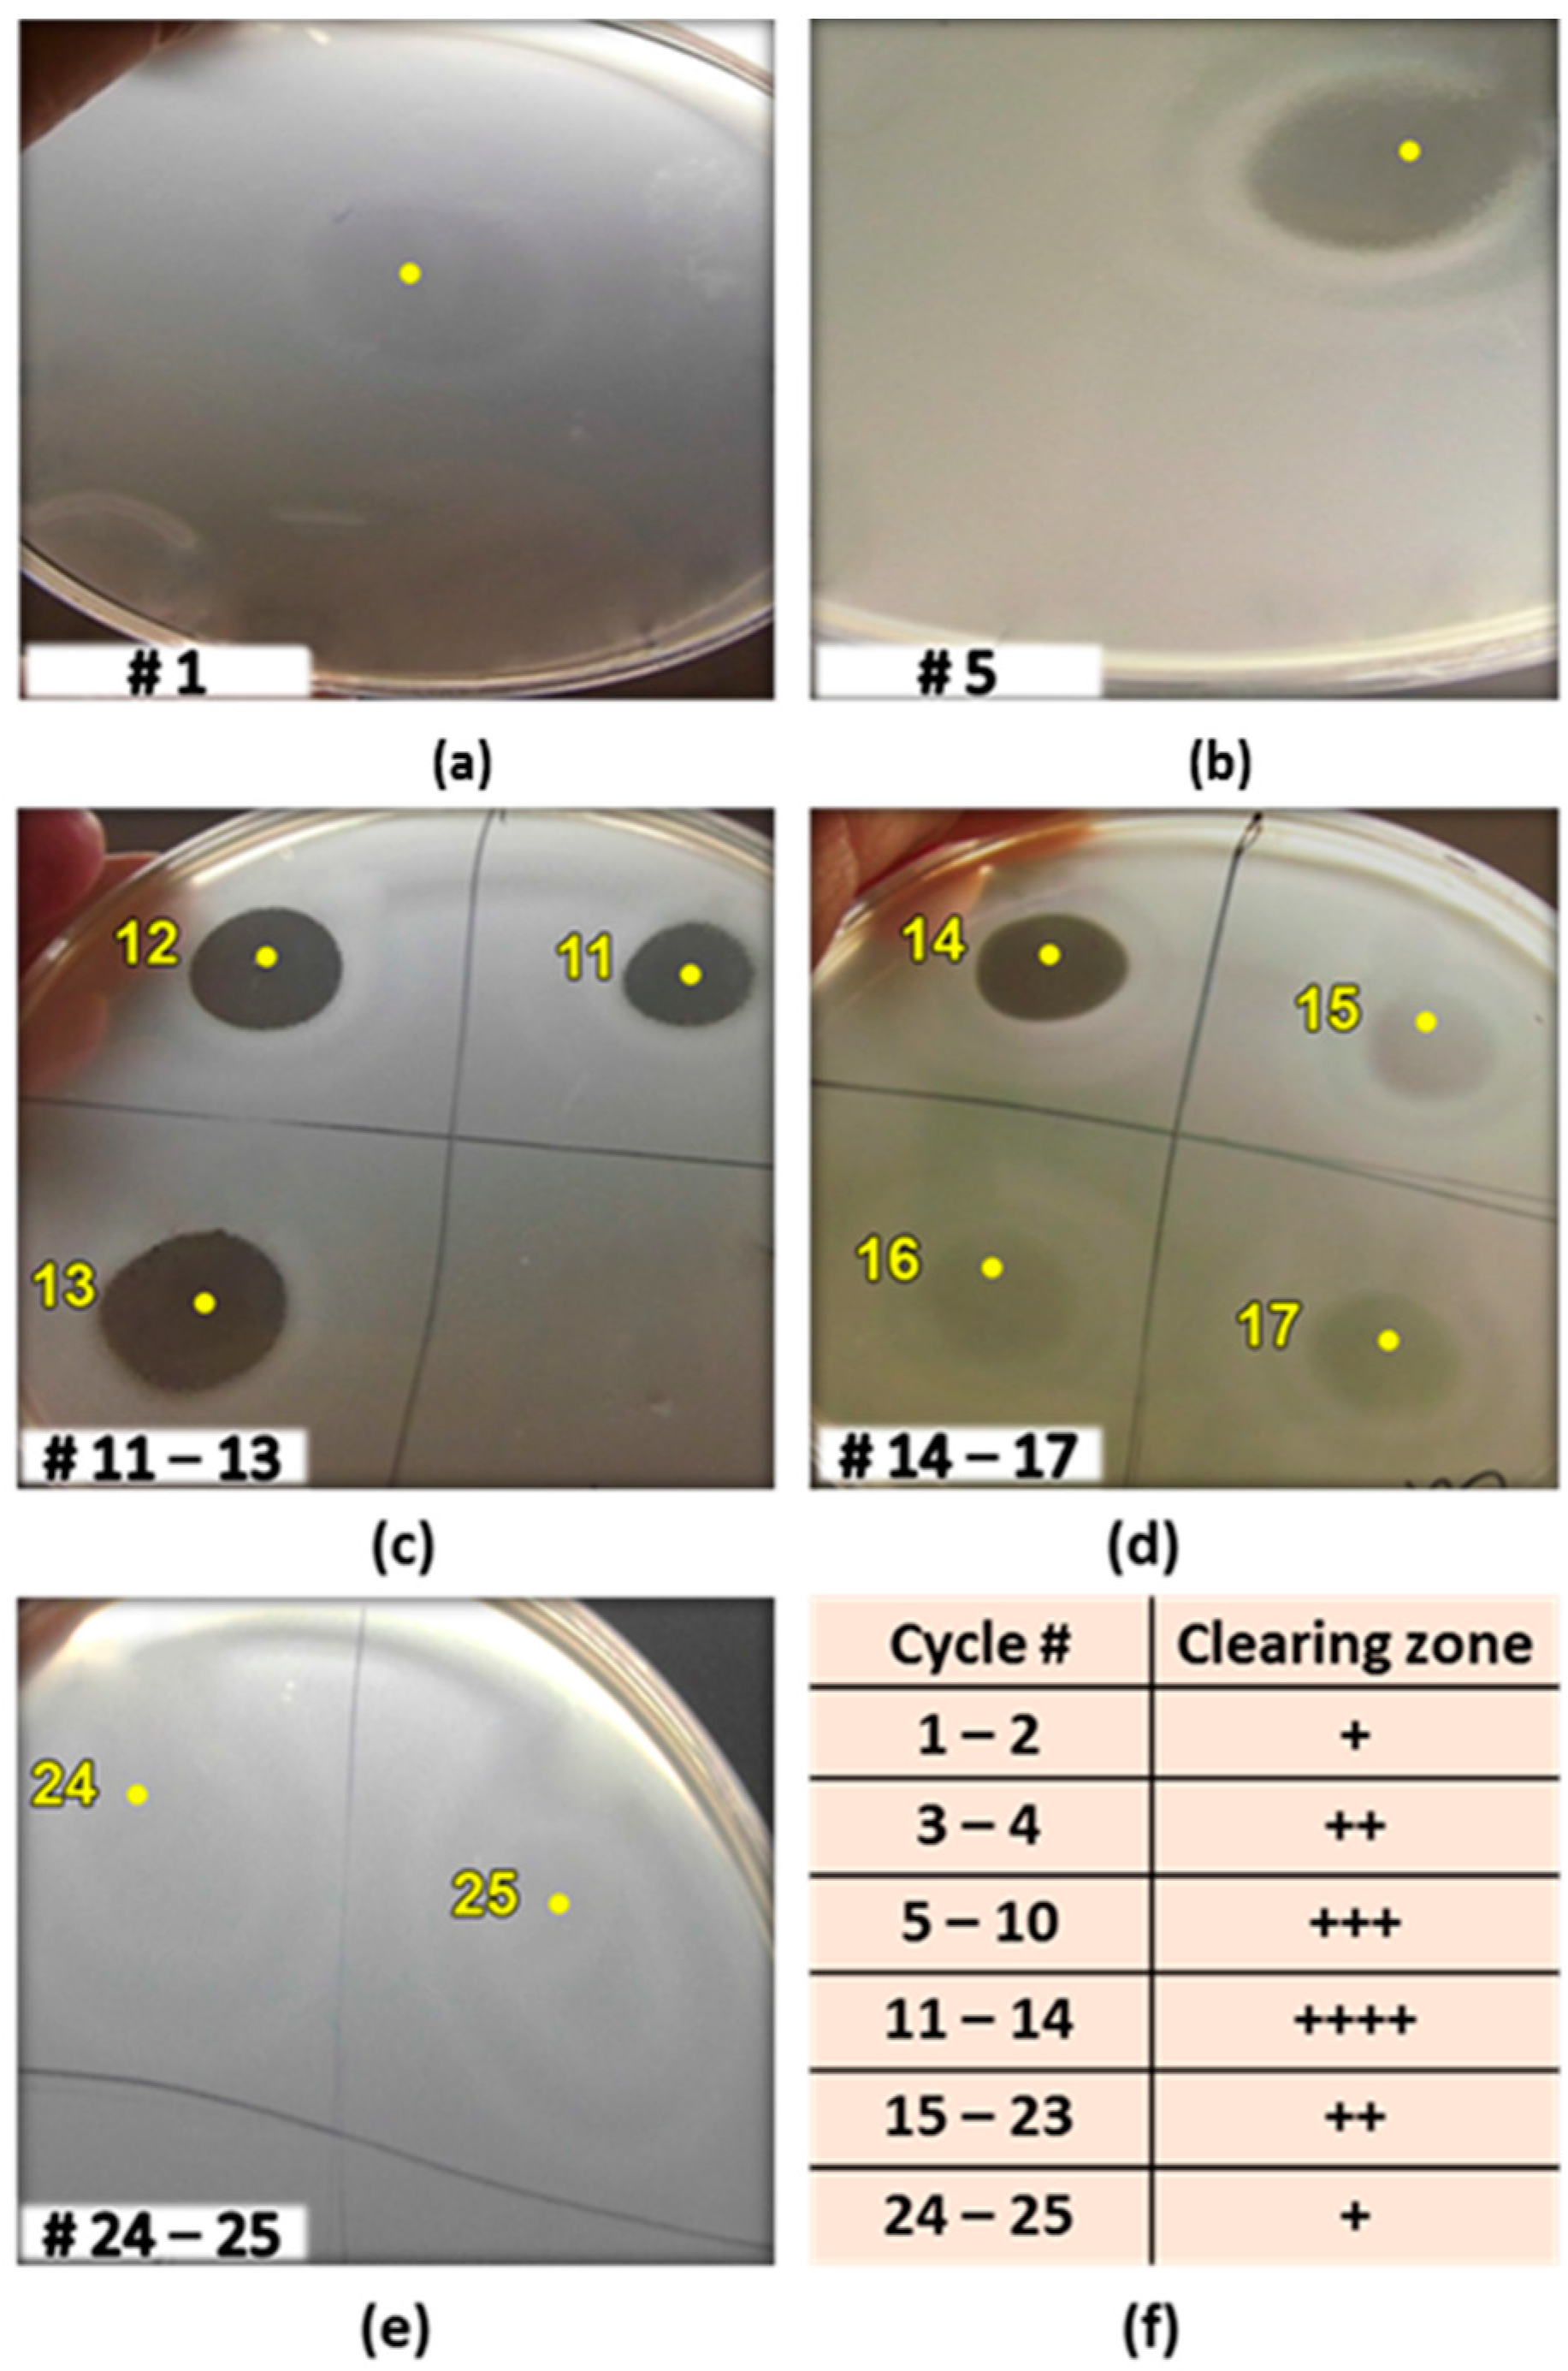

Antimicrobial Protein Candidates from the Thermophilic Geobacillus sp. Strain ZGt-1: Production, Proteomics, and Bioinformatics Analysis
Abstract
:1. Introduction
2. Results and Discussion
2.1. Isolation, Identification, and Characterization of the Isolate
2.2. Antibacterial Activity of Geobacillus sp. ZGt-1
2.3. Production of the Antibacterial Substance(s) Using Immobilized Cells in Sequential Batch Mode with Cell Recycling
2.4. Antimicrobial Proteins Produced by Strain ZGt-1
2.5. Targeted Proteomics Analysis of the Antibacterial Protein-Containing Gel Samples
2.6. Prediction of Antibacterial Potency Based on Physicochemical Properties
2.7. In Silico Prediction of the Antibacterial Potency
2.8. Identified Protein Sequences Matching Parts of Antimicrobial Enzymes
3. Materials and Methods
3.1. Materials
3.2. Isolation of Bacteria from Zara Hot Spring in Jordan, Strain Maintenance and Cultivation Conditions
3.3. Identification of the Bacterial Isolates by 16S rRNA Sequencing
3.4. Detection of Antibacterial Activity of Geobacillus sp. ZGt-1
3.4.1. Agar-Deferred Spot Method
3.4.2. Spot-on-Lawn Method
3.5. Sensitivity of the Antibacterial Substance(s) to Proteolysis by Proteinase K
3.6. Batch Production of the Antibacterial Substance(s) in Shake Flasks by Free Cells of Geobacillus sp. ZGt-1
3.7. Sequential Batch Production of the Antibacterial Substance(s) in Shake Flasks Using Immobilized Cells of Geobacillus sp. ZGt-1
3.8. Towards Identification of the Antibacterial Protein Candidates
3.9. Sensitivity of the Antibacterial Protein(s) to Heat
3.10. Sensitivity of the Antibacterial Protein(s) to SDS and Fractionation by SDS-PAGE
3.11. Targeted Proteomics Analysis of the Antibacterially Active Protein Fraction Using Mass Spectrometry
3.12. UniProt Database Search for Identification of the MS/MS-Identified Proteins Using BLASTp
3.13. In Silico Analysis of the Proteins Identified as Possible Antimicrobials
3.13.1. Calculating the Physicochemical Properties of the Uncharacterized Proteins
3.13.2. Prediction of Antimicrobial Activity of the Uncharacterized Proteins
3.13.3. Domain Architecture Analysis of Antimicrobial Enzyme Sequences
4. Conclusions
Supplementary Materials
Acknowledgments
Author Contributions
Conflicts of Interest
Abbreviations
| Amidase | N-acetylmuramoyl-l-alanine amidase |
| AMP | Antimicrobial peptide/protein |
| ANN | Artificial neural network |
| APD3 | Antimicrobial peptide database |
| CAMPR3 | The collection of anti-microbial peptides |
| DA | Discriminant analysis |
| dd-carboxypeptidase | Serine-type d-alanyl-d-alanine carboxypeptidase |
| DTT | Dithiothreitol |
| GRAVY | Grand average of hydropathicity |
| LPS | Lipopolysaccharide |
| LC-MS/MS | Liquid chromatography tandem mass spectrometry |
| meso-DAP | Meso-diaminopimelic acid |
| MH | Mueller Hinton culture medium |
| Na4vSS | Normalized average of aggregation propensity |
| NAMP | Non-antimicrobial peptide/protein |
| PG | Peptidoglycan |
| pI | Isoelectric point |
| RF | Random forests |
| SVM | Support vector machines |
References
- Hibbing, M.E.; Fuqua, C.; Parsek, M.R.; Peterson, S.B. Bacterial competition: Surviving and thriving in the microbial jungle. Nat. Rev. Microbiol. 2010, 8, 15–25. [Google Scholar] [CrossRef] [PubMed]
- Wright, G.D.; Sutherland, A.D. New strategies for combating multidrug-resistant bacteria. Trends Mol. Med. 2007, 13, 260–267. [Google Scholar] [CrossRef] [PubMed]
- Ravot, G.; Masson, J.M.; Lefevre, F. 34 Applications of extremophiles: The industrial screening of extremophiles for valuable biomolecules. Method Microbiol. 2006, 35, 785–813. [Google Scholar]
- Danesh, A.; Mamo, G.; Mattiasson, B. Production of haloduracin by Bacillus halodurans using solid-state fermentation. Biotechnol. Lett. 2011, 33, 1339–1344. [Google Scholar] [CrossRef] [PubMed]
- Esikova, T.Z.; Temirov, Y.V.; Sokolov, S.L.; Alakhov, Y.B. Secondary antimicrobial metabolites produced by thermophilic Bacillus spp. strains VK2 and VK21. Appl. Biochem. Microbiol. 2002, 38, 226–231. [Google Scholar]
- McClerren, A.L.; Cooper, L.E.; Quan, C.; Thomas, P.M.; Kelleher, N.L.; van der Donk, W.A. Discovery and in vitro biosynthesis of haloduracin, a two-component lantibiotic. Proc. Natl. Acad. Sci. USA 2006, 103, 17243–17248. [Google Scholar] [CrossRef] [PubMed]
- Phoebe, C.H.; Combie, J.; Albert, F.G.; van Tran, K.; Cabrera, J.; Correira, H.J.; Guo, Y.H.; Lindermuth, J.; Rauert, N.; Galbraith, W.; et al. Extremophilic organisms as an unexplored source of antifungal compounds. J. Antibiot. 2001, 54, 56–65. [Google Scholar] [PubMed]
- Garg, N.; Tang, W.; Goto, Y.; Nair, S.K.; van der Donk, W.A. Lantibiotics from Geobacillus thermodenitrificans. Proc. Natl. Acad. Sci. USA 2012, 109, 5241–5246. [Google Scholar] [CrossRef] [PubMed]
- Pokusaeva, K.; Kuisiene, N.; Jasinskyte, D.; Rutiene, K.; Saleikiene, J.; Chitavichius, D. Novel bacteriocins produced by Geobacillus stearothermophilus. Cent. Eur. J. Biol. 2009, 4, 196–203. [Google Scholar] [CrossRef]
- Xia, K.; Zhang, S.J.; Solina, B.A.; Barquera, B.; Colon, W. Do prokaryotes have more kinetically stable proteins than eukaryotic organisms? Biochemistry 2010, 49, 7239–7241. [Google Scholar] [CrossRef] [PubMed]
- Viedma, P.M.; Abriouel, H.; Ben Omar, N.; Lopez, R.L.; Valdivia, E.; Galvez, A. Inactivation of Geobacillus stearothermophilus in canned food and coconut milk samples by addition of enterocin AS-48. Food Microbiol. 2009, 26, 289–293. [Google Scholar] [CrossRef] [PubMed]
- Wiegand, S.; Rabausch, U.; Chow, J.; Daniel, R.; Streit, W.R.; Liesegang, H. Complete genome sequence of Geobacillus sp. strain GHH01, a thermophili lipase-secreting bacterium. Genome Announc. 2013, 1, e00092. [Google Scholar] [CrossRef] [PubMed]
- Wyckoff, T.J.; Taylor, J.A.; Salama, N.R. Beyond growth: Novel functions for bacterial cell wall hydrolases. Trends Microbiol. 2012, 20, 540–547. [Google Scholar] [CrossRef] [PubMed]
- Weidenmaier, C.; Peschel, A. Teichoic acids and related cell-wall glycopolymers in Gram-positive physiology and host interactions. Nat. Rev. Microbiol. 2008, 6, 276–287. [Google Scholar] [CrossRef] [PubMed]
- Scheffers, D.-J.; Pinho, M.G. Bacterial cell wall synthesis: New insights from localization studies. Microbiol. Mol. Biol. Rev. 2005, 69, 585–607. [Google Scholar] [CrossRef] [PubMed]
- Brogden, K.A. Antimicrobial peptides: Pore formers or metabolic inhibitors in bacteria? Nat. Rev. Microbiol. 2005, 3, 238–250. [Google Scholar] [CrossRef] [PubMed]
- Guo, L.; Lim, K.B.; Poduje, C.M.; Daniel, M.; Gunn, J.S.; Hackett, M.; Miller, S.I. Lipid a acylation and bacterial resistance against vertebrate antimicrobial peptides. Cell 1998, 95, 189–198. [Google Scholar] [CrossRef]
- Guilhelmelli, F.; Vilela, N.; Albuquerque, P.; Derengowski, L.D.S.; Silva-Pereira, I.; Kyaw, C.M. Antibiotic development challenges: The various mechanisms of action of antimicrobial peptides and of bacterial resistance. Front. Microbiol. 2013, 4, 353. [Google Scholar] [CrossRef] [PubMed]
- Netea, M.G.; Kullberg, B.J.; Joosten, L.A.B.; Sprong, T.; Verschueren, I.; Boerman, O.C.; Amiot, F.; van den Berg, W.B.; van der Meer, J.W.M. Lethal Escherichia coli and Salmonella typhimurium endotoxemia is mediated through different pathways. Eur. J. Immunol. 2001, 31, 2529–2538. [Google Scholar] [CrossRef]
- Logan, N.A.; de Vos, P. Genus I. Bacillus. In Bergey’s Manual of Systematic Bacteriology, 2nd ed.; Whitman, W.B., Ed.; Springer: Dordrecht, The Netherlands; New York, NY, USA, 2009; Volume 3. [Google Scholar]
- Bhavsar, A.P.; Brown, E.D. Cell wall assembly in Bacillus subtilis: How spirals and spaces challenge paradigms. Mol. Microbiol. 2006, 60, 1077–1090. [Google Scholar] [CrossRef] [PubMed]
- Parisien, A.; Allain, B.; Zhang, J.; Mandeville, R.; Lan, C.Q. Novel alternatives to antibiotics: Bacteriophages, bacterial cell wall hydrolases, and antimicrobial peptides. J. Appl. Microbiol. 2008, 104, 1–13. [Google Scholar] [CrossRef] [PubMed]
- Navarre, W.W.; Schneewind, O. Surface proteins of Gram-positive bacteria and mechanisms of their targeting to the cell wall envelope. Microbiol. Mol. Biol. Rev. 1999, 63, 174–229. [Google Scholar] [PubMed]
- Nilsen, T.; Nes, I.F.; Holo, H. Enterolysin A, a cell wall-degrading bacteriocin from Enterococcus faecalis LMG 2333. Appl. Environ. Microbiol. 2003, 69, 2975–2984. [Google Scholar] [CrossRef] [PubMed]
- Lacroix, C.; Grattepanche, F.; Doleyres, Y.; Bergmaier, D. Immobilised cell technologies for the dairy industry. In Applications of Cell Immobilisation Biotechnology; Nedovic, V., Willaert, R., Eds.; Springer: Dordrecht, The Netherlands, 2005. [Google Scholar]
- Doleyres, Y.; Lacroix, C. Technologies with free and immobilised cells for probiotic bifidobacteria production and protection. Int. Dairy J. 2005, 15, 973–988. [Google Scholar] [CrossRef]
- Alkhalili, R.N.; Hatti-Kaul, R.; Canbäck, B. Genome sequence of Geobacillus sp. strain ZGt-1, an antibacterial peptide-producing bacterium from hot springs in Jordan. Genome Announc. 2015, 3, e00799-15. [Google Scholar] [CrossRef] [PubMed]
- Manning, M.; Colon, W. Structural basis of protein kinetic stability: Resistance to sodium dodecyl sulfate suggests a central role for rigidity and a bias toward β-sheet structure. Biochemistry 2004, 43, 11248–11254. [Google Scholar] [CrossRef] [PubMed]
- Rath, A.; Glibowicka, M.; Nadeau, V.G.; Chen, G.; Deber, C.M. Detergent binding explains anomalous SDS-PAGE migration of membrane proteins. Proc. Natl. Acad. Sci. USA 2009, 106, 1760–1765. [Google Scholar] [CrossRef] [PubMed]
- Rath, A.; Nadeau, V.G.; Poulsen, B.E.; Ng, D.P.; Deber, C.M. Novel hydrophobic standards for membrane protein molecular weight determinations via sodium dodecyl sulfate-polyacrylamide gel electrophoresis. Biochemistry 2010, 49, 10589–10591. [Google Scholar] [CrossRef] [PubMed]
- Bishop, B.M.; Juba, M.L.; Devine, M.C.; Barksdale, S.M.; Rodriguez, C.A.; Chung, M.C.; Russo, P.S.; Vliet, K.A.; Schnur, J.M.; van Hoek, M.L. Bioprospecting the American alligator (Alligator mississippiensis) host defense peptidome. PLoS ONE 2015, 10, e0117394. [Google Scholar] [CrossRef] [PubMed]
- Dziuba, B.; Dziuba, M. New milk protein-derived peptides with potential antimicrobial activity: An approach based on bioinformatic studies. Int. J. Mol. Sci. 2014, 15, 14531–14545. [Google Scholar] [CrossRef] [PubMed]
- Chang, K.Y.; Lin, T.P.; Shih, L.Y.; Wang, C.K. Analysis and prediction of the critical regions of antimicrobial peptides based on conditional random fields. PLoS ONE 2015, 10, e0119490. [Google Scholar] [CrossRef] [PubMed]
- Zelezetsky, I.; Tossi, A. α-Helical antimicrobial peptides—Using a sequence template to guide structure-activity relationship studies. BBA Biomembr. 2006, 1758, 1436–1449. [Google Scholar] [CrossRef] [PubMed]
- Melo, M.N.; Ferre, R.; Castanho, M.A.R.B. Antimicrobial peptides: Linking partition, activity and high membrane-bound concentrations. Nat. Rev. Microbiol. 2009, 7, 245–250. [Google Scholar] [CrossRef] [PubMed]
- Torrent, M.; Andreu, D.; Nogues, V.M.; Boix, E. Connecting peptide physicochemical and antimicrobial properties by a rational prediction model. PLoS ONE 2011, 6, e16968. [Google Scholar] [CrossRef] [PubMed]
- Jiang, Z.Q.; Vasil, A.I.; Hale, J.D.; Hancock, R.E.W.; Vasil, M.L.; Hodges, R.S. Effects of net charge and the number of positively charged residues on the biological activity of amphipathic α-helical cationic antimicrobial peptides. Biopolymers 2008, 90, 369–383. [Google Scholar] [CrossRef] [PubMed]
- Boman, H.G. Antibacterial peptides: Basic facts and emerging concepts. J. Intern. Med. 2003, 254, 197–215. [Google Scholar] [CrossRef] [PubMed]
- Gasteiger, E.; Hoogland, C.; Gattiker, A.; Duvaud, S.; Wilkins, M.R.; Appel, R.D.; Bairoch, A. Protein identification and analysis tools on the ExPASy server. In The Proteomics Protocols Handbook; Walker, J.M., Ed.; Humana Press: Totowa, NJ, USA, 2005. [Google Scholar]
- Ikai, A. Thermostability and aliphatic index of globular proteins. J. Biochem. 1980, 88, 1895–1898. [Google Scholar] [PubMed]
- Conchillo-Sole, O.; de Groot, N.S.; Aviles, F.X.; Vendrell, J.; Daura, X.; Ventura, S. AGGRESCAN: A server for the prediction and evaluation of “hot spots” of aggregation in polypeptides. BMC Bioinform. 2007, 8, 65. [Google Scholar] [CrossRef] [PubMed]
- Yoo, W.G.; Lee, S.; Lee, M.R.; Yun, M.R.; Kwon, T.; Kim, D.W. Genome-wide identification of antimicrobial peptides in the liver fluke, Clonorchis sinensis. Bioinformation 2015, 11, 17–20. [Google Scholar] [CrossRef] [PubMed]
- Waghu, F.H.; Barai, R.S.; Gurung, P.; Idicula-Thomas, S. CAMPR3: A database on sequences, structures and signatures of antimicrobial peptides. Nucleic Acids Res. 2016, 44, D1094–D1097. [Google Scholar] [CrossRef] [PubMed]
- Wang, G.; Li, X.; Wang, Z. APD3: The antimicrobial peptide database as a tool for research and education. Nucleic Acids Res. 2016, 44, D1087–D1093. [Google Scholar] [CrossRef] [PubMed]
- Torrent, M.; Di Tommaso, P.; Pulido, D.; Nogues, M.V.; Notredame, C.; Boix, E.; Andreu, D. AMPA: An automated web server for prediction of protein antimicrobial regions. Bioinformatics 2012, 28, 130–131. [Google Scholar] [CrossRef] [PubMed]
- Waghu, F.H.; Gopi, L.; Barai, R.S.; Ramteke, P.; Nizami, B.; Idicula-Thomas, S. CAMP: Collection of sequences and structures of antimicrobial peptides. Nucleic Acids Res. 2014, 42, D1154–D1158. [Google Scholar] [CrossRef] [PubMed]
- Wang, Z.; Wang, G. APD: The Antimicrobial Peptide Database. Nucleic Acids Res. 2004, 32, D590–D592. [Google Scholar] [CrossRef] [PubMed]
- Borysowski, J.; Górski, A. Enzybiotics and their potential applications in medicine. In Enzybiotics: Antibiotic Enzymes as Drugs and Therapeutics; Villa, T.G., Veiga-Crespo, P., Eds.; John Wiley & Sons, Inc.: Hoboken, NJ, USA, 2010. [Google Scholar]
- Shockman, G.D.; Höltje, J.-V. Microbial peptidoglycan (murein) hydrolases. In Bacterial Cell Wall; Ghuysen, J.-M.G., Hakenbeck, R., Eds.; Elsevier B.V.: Amsterdam, The Netherlands, 1994. [Google Scholar]
- Jones, P.; Binns, D.; Chang, H.Y.; Fraser, M.; Li, W.Z.; McAnulla, C.; McWilliam, H.; Maslen, J.; Mitchell, A.; Nuka, G.; et al. InterProScan 5: Genome-scale protein function classification. Bioinformatics 2014, 30, 1236–1240. [Google Scholar] [CrossRef] [PubMed]
- Zhang, Z.; Schwartz, S.; Wagner, L.; Miller, W. A greedy algorithm for aligning DNA sequences. J. Comput. Biol. 2000, 7, 203–214. [Google Scholar] [CrossRef] [PubMed]
- Faye, T.; Brede, D.A.; Langsrud, T.; Nes, I.F.; Holo, H. An antimicrobial peptide is produced by extracellular processing of a protein from Propionibacterium jensenii. J. Bacteriol. 2002, 184, 3649–3656. [Google Scholar] [CrossRef] [PubMed]
- Bhunia, A.K.; Johnson, M.C.; Ray, B. Direct detection of an antimicrobial peptide of pediococcus-acidilactici in sodium dodecyl sulfate-polyacrylamide gel-electrophoresis. J. Ind. Microbiol. 1987, 2, 319–322. [Google Scholar] [CrossRef]
- Perkins, D.N.; Pappin, D.J.C.; Creasy, D.M.; Cottrell, J.S. Probability-based protein identification by searching sequence databases using mass spectrometry data. Electrophoresis 1999, 20, 3551–3567. [Google Scholar] [CrossRef]
- Hyatt, D.; Chen, G.L.; LoCascio, P.F.; Land, M.L.; Larimer, F.W.; Hauser, L.J. Prodigal: Prokaryotic gene recognition and translation initiation site identification. BMC Bioinform. 2010, 11, 119. [Google Scholar] [CrossRef] [PubMed]
- Altschul, S.F.; Madden, T.L.; Schaffer, A.A.; Zhang, J.; Zhang, Z.; Miller, W.; Lipman, D.J. Gapped BLAST and PSI-BLAST: A new generation of protein database search programs. Nucleic Acids Res. 1997, 25, 3389–3402. [Google Scholar] [CrossRef] [PubMed]
- The UniProt Consortium. UniProt: A hub for protein information. Nucleic Acids Res. 2015, 43, D204–D212. [Google Scholar]

| Query ID | MS Score | Mw (kDa) 1 | Homologous Protein Name 2 | UniProt ID |
|---|---|---|---|---|
| 2_80 | 253 | 17.118 | 2-C-methyl-d-erythritol 2,4-cyclodiphosphate synthase | G8N0X9 |
| 23_188 | 469 | 16.072 | 6,7-Dimethyl-8-ribityllumazine synthase | L8A0J9 |
| 28_41 | 488 | 20.475 | ATP synthase subunit b | G8MZV8 |
| 186_1_184_1 | 219 | 22.862 | Capsid protein | A0A0K9I0I6 |
| 190_1_188_1 | 243 | 15.718 | Capsid protein | A0A0K9I0I6 |
| 23_393 | 258 | 23.554 | Deoxyribose-phosphate aldolase | A0A063YQK6 |
| 4_30 | 219 | 17.987 | DinB family protein | U2WSJ5 |
| 26_1 | 403 | 19.041 | Flagellin | L8A2E4 |
| 23_543 | 517 | 16.846 | Hypothetical conserved protein | Q5KWM5 |
| 23_84 | 241 | 19.549 | Menaquinol-cytochrome c reductase iron-sulfur subunit | S7U299 |
| 6_3 | 293 | 17.044 | N5-carboxyaminoimidazole ribonucleotide | Q5L3D8 |
| 23_103 | 610 | 16.741 | Nucleoside diphosphate kinase | G8MZM9 |
| 13_48 | 231 | 20.528 | Peptide deformylase | Q5L138 |
| 23_492 | 803 | 21.126 | Peroxiredoxin | Q5KWS6 |
| 23_704 | 866 | 18.266 | Probable thiol peroxidase | Q5KW64 |
| 28_65 | 267 | 23.049 | Probable transaldolase | L8A4Q9 |
| 23_775 | 357 | 16.545 | Starvation-induced protein controlled by σ-B | Q5KVZ0 |
| 25_145 | 314 | 27.457 | Triose phosphate isomerase | A0A063YNF6 |
| 4_4 | 432 | 19.025 | Uncharacterized protein | Q5L3L9 |
| 6_35 | 406 | 13.884 | Uncharacterized protein | Q5L3A8 |
| 18_68 | 208 | 27.963 | Uroporphyrin-III C-methyltransferase | Q5KZ09 |
| 21_9 | 315 | 19.432 | YceI family protein/uncharacterized protein | G8MXK2 |
| Physicochemical Properties | ||||
|---|---|---|---|---|
| Property | Protein Query ID | |||
| 6_35 | 23_543 | 4_4 | ||
| Length | 129 | 153 | 173 | |
| Molecular weight (kDa) | 13.8927 | 16.8564 | 18.979.1 | |
| Net charge | +2 | +2 | +1 | |
| pI | 8.80 | 8.61 | 7.72 | |
| Instability index | 14.04 | 17.61 | 36.7 | |
| Aliphatic index | 80.08 | 110.33 | 96.76 | |
| GRAVY index | −0.044 | −0.257 | −0.253 | |
| Boman index (kcal/mol) | 1.12 | 1.57 | 1.19 | |
| Na4vSS | 5.3 | −6.6 | −2.4 | |
| Number of aggregation hot spot regions | 3 | 6 | 6 | |
| Total hydrophobic ratio | 40% | 39% | 36% | |
| Potential of forming amphipathic helix | Yes | Yes | Yes | |
| Number of hydrophobic residues on the same side | ≥38 | ≥42 | ≥31 | |
| Algorithm Models | ||||
| CAMPR3 Models | SVM | 1.000 1 | 1.000 1 | 1.000 1 |
| RF | 0.987 1 | 0.9575 1 | 0.991 1 | |
| DA | 1.000 1 | 1.000 1 | 1.000 1 | |
| ANN | NAMP 2 | AMP 3 | NAMP 2 | |
| APD3 | AMP 3 | AMP 3 | AMP 3 | |
| AMPA | NAMP 2 | AMP 3 | NAMP 2 | |
| (0.86) 1 | ||||
| Summary of the Fulfilled Antimicrobial Potential Parameters Inferred from the Physicochemical Properties and Prediction Algorithms | ||||
| Physicochemical properties | All | All | Majority | |
| Prediction algorithms | Majority | All | Majority | |
© 2016 by the authors; licensee MDPI, Basel, Switzerland. This article is an open access article distributed under the terms and conditions of the Creative Commons Attribution (CC-BY) license (http://creativecommons.org/licenses/by/4.0/).
Share and Cite
Alkhalili, R.N.; Bernfur, K.; Dishisha, T.; Mamo, G.; Schelin, J.; Canbäck, B.; Emanuelsson, C.; Hatti-Kaul, R. Antimicrobial Protein Candidates from the Thermophilic Geobacillus sp. Strain ZGt-1: Production, Proteomics, and Bioinformatics Analysis. Int. J. Mol. Sci. 2016, 17, 1363. https://doi.org/10.3390/ijms17081363
Alkhalili RN, Bernfur K, Dishisha T, Mamo G, Schelin J, Canbäck B, Emanuelsson C, Hatti-Kaul R. Antimicrobial Protein Candidates from the Thermophilic Geobacillus sp. Strain ZGt-1: Production, Proteomics, and Bioinformatics Analysis. International Journal of Molecular Sciences. 2016; 17(8):1363. https://doi.org/10.3390/ijms17081363
Chicago/Turabian StyleAlkhalili, Rawana N., Katja Bernfur, Tarek Dishisha, Gashaw Mamo, Jenny Schelin, Björn Canbäck, Cecilia Emanuelsson, and Rajni Hatti-Kaul. 2016. "Antimicrobial Protein Candidates from the Thermophilic Geobacillus sp. Strain ZGt-1: Production, Proteomics, and Bioinformatics Analysis" International Journal of Molecular Sciences 17, no. 8: 1363. https://doi.org/10.3390/ijms17081363
APA StyleAlkhalili, R. N., Bernfur, K., Dishisha, T., Mamo, G., Schelin, J., Canbäck, B., Emanuelsson, C., & Hatti-Kaul, R. (2016). Antimicrobial Protein Candidates from the Thermophilic Geobacillus sp. Strain ZGt-1: Production, Proteomics, and Bioinformatics Analysis. International Journal of Molecular Sciences, 17(8), 1363. https://doi.org/10.3390/ijms17081363

